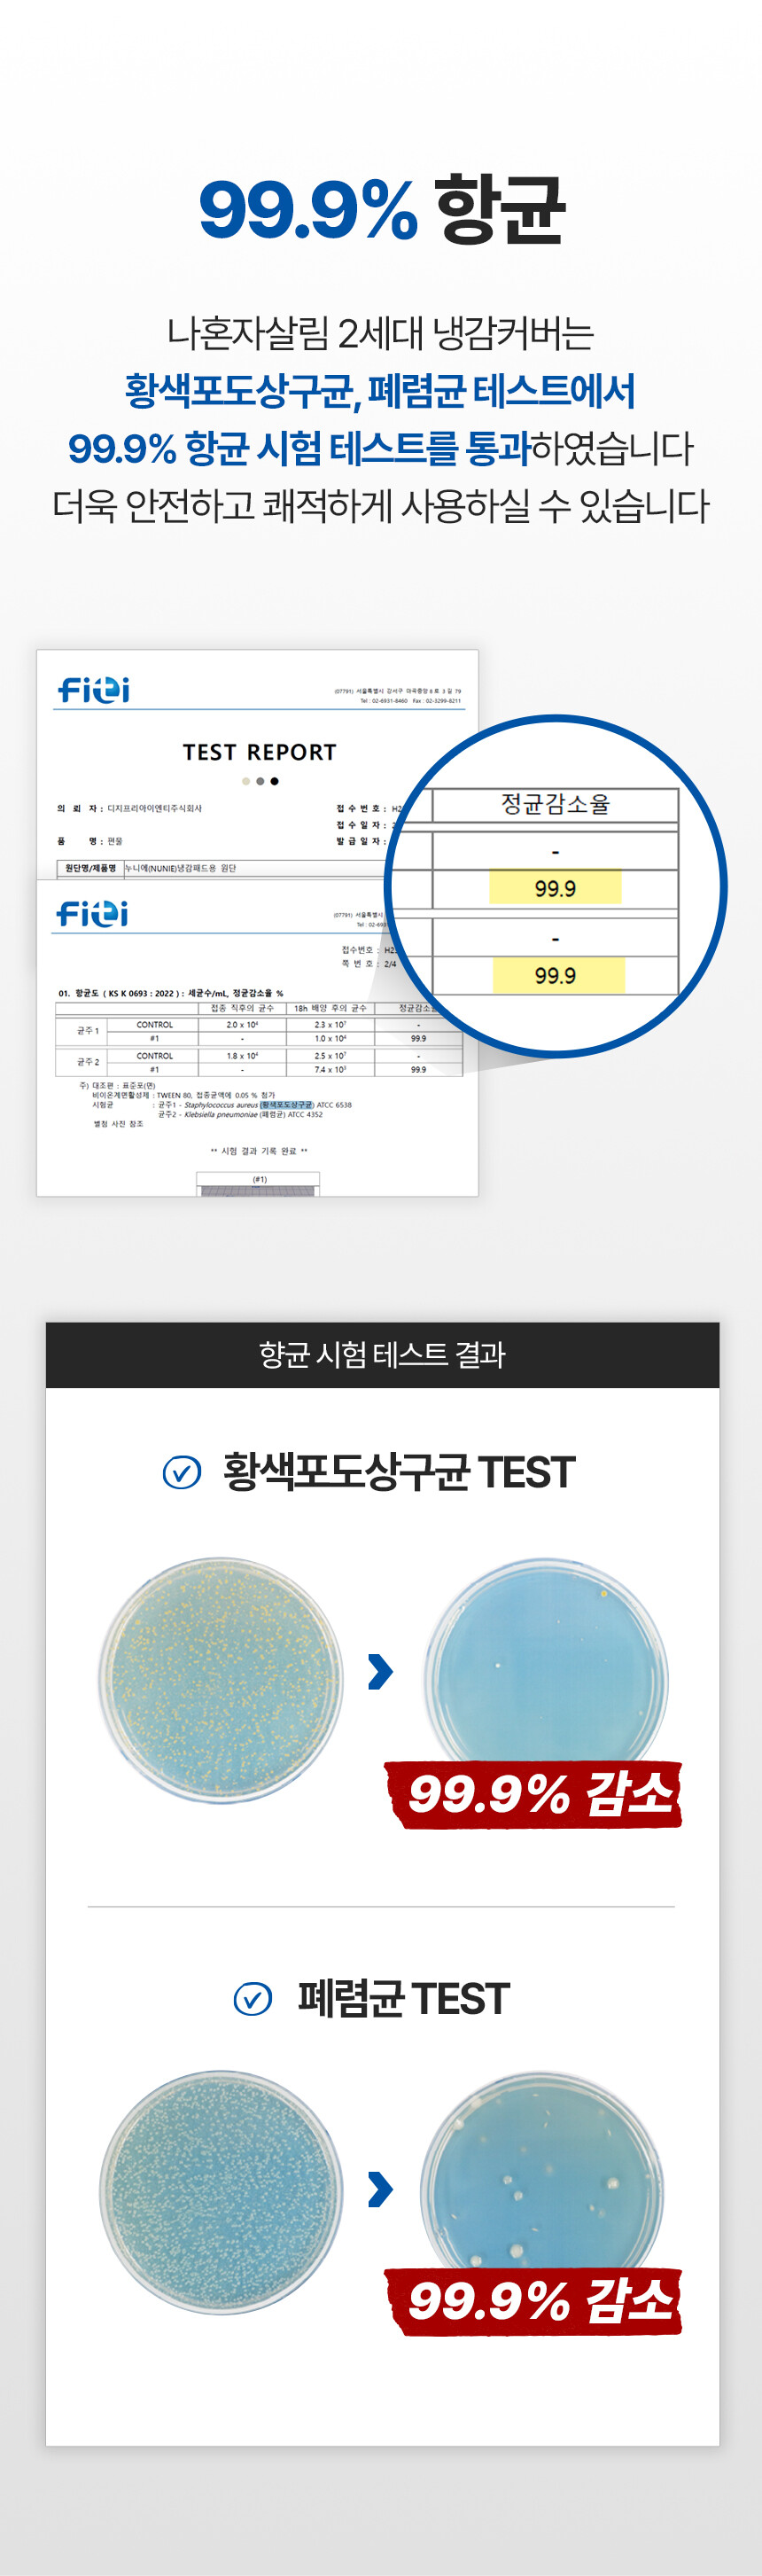

25년형 나혼자살림 여름 냉감베개커버
22,900원
42,900원
사이즈선택
선택하세요.
선택하세요.
40cm*60cm
50cm*70cm
(+3,000원)
주문 수량
0개
총 상품 금액
0원

[ 배송안내 ]
제품명 : 25년형 나혼자살림 여름 냉감베개커버
배송 방법 : 택배
출고지 : (주)위아인터내셔널 서울시 금천구 두산로 70, 5층 529호 (현대지식산업센터)
[배송 비용]
- 기본 배송비 : 3,500원
- 도선산간지역 추가 배송비 : 제주 4,000원 / 제주외 도서산간 : 5,000원
[√ 교환 및 반품 배송지]
교환 및 반품 배송지 : (주)위아인터내셔널 서울시 금천구 두산로 70, 5층 529호 (현대지식산업센터)
[단순 변심 반품 / 교환 배송비]
- 편도 배송비 3,500원
- 왕복 배송비 : 7,000원
[현금영수증 발급 신청 방법]
나혼자살림 1:1 채팅 상담을 이용해주세요!
무통장 입금 후 현급영수증 발급을 원하실 때는, 온라인 채팅상담으로 연락주시면 안내도와드리겠습니다.
[배송기간 및 조회안내]
발송된 송장번호 확인 후 택배사 공식홈페이지에서 조회가 가능합니다.
* 송장번호 조회의 경우 시스템 연동 문제상 네이버 송장 조회 검색이 아닌 택배사 공식 홈페이지에서
직접 조회하시는 것이 발송 현황과 담당 영업소 연락처 확인이 정확합니다.
정확한 배송 문의는 택배사 고객센터로 문의주시면 확인 가능합니다.
25년형 나혼자살림 여름 냉감베개커버
22,900원
42,900원
사이즈선택
선택하세요.
선택하세요.
40cm*60cm
50cm*70cm
(+3,000원)
주문 수량
0개
총 상품 금액
0원

